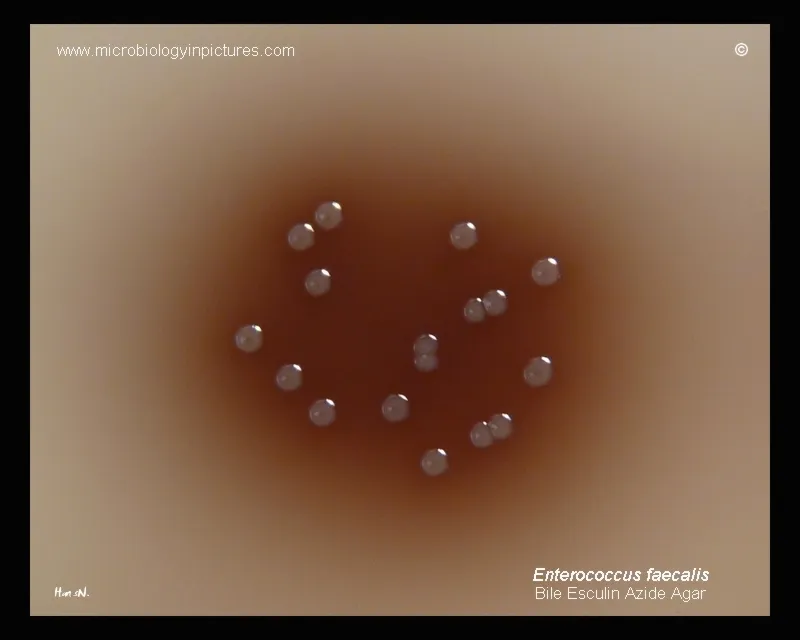
Enterococcus faecalis on Bile Esculin Azide Agar

Enterococci - Gut's Hardy Commandos

- Gram ⊕ cocci, catalase ⊝. Can grow in 6.5% NaCl and bile.
- Normal colonic flora that become pathogenic.
- Commonly cause UTIs, biliary tract infections, and subacute endocarditis.
- 📌 Mnemonic: "DO U ♥️ E?" (Endocarditis, UTI, Biliary tract).
⭐ Vancomycin-Resistant Enterococci (VRE) are a major cause of nosocomial infections, often requiring treatment with linezolid or daptomycin.
Clinical Hits - The UTI & Endo Story
- Urinary Tract Infections (UTIs):
- A leading cause of nosocomial UTIs, especially in catheterized, elderly patients.
- Often follows GU instrumentation.
- Infective Endocarditis (IE):
- Common cause of subacute bacterial endocarditis (SBE).
- Typically from a GI/GU source; suspect after procedures like cystoscopy.
- Affects native and prosthetic valves.
- Other Infections: Biliary tract infections, bacteremia, and wound infections (intra-abdominal).
- 📌 Mnemonic: Think "DO U ❤️ Biliary?" for D-ocarditis, U-TI, and Biliary tract infections.
⭐ Enterococcus faecium is more dangerous than E. faecalis due to its higher likelihood of vancomycin resistance (VRE), a major clinical challenge.

Lab ID - The Salty Survivor
- Gram-positive cocci, arranged in pairs or short chains.
- Catalase-negative (distinguishes from Staphylococcus).
- PYR-positive (pyrrolidonyl arylamidase test is positive).
- Key Feature: Tolerates and grows in hypertonic (6.5%) NaCl broth.
- Bile esculin positive: Hydrolyzes esculin even in the presence of bile, turning the specialized agar dark brown or black.
⭐ While both Enterococci and Group D Streptococci (S. gallolyticus) are bile esculin positive, only Enterococci reliably grow in 6.5% NaCl. This salt tolerance is the crucial differentiating test.
Treatment - The Resistance Challenge
- Intrinsic Resistance: Enterococci show natural resistance to cephalosporins, clindamycin, and TMP-SMX. For bactericidal effect, a cell wall agent (e.g., ampicillin) must be combined with an aminoglycoside (e.g., gentamicin) for synergy.
- Vancomycin-Resistant Enterococci (VRE): A critical nosocomial threat. Resistance arises from modifying the peptidoglycan target from $D-Ala-D-Ala$ to $D-Ala-D-Lac$, preventing vancomycin binding.
- VRE Management:
- Linezolid
- Daptomycin
- Tigecycline
⭐ Linezolid and Daptomycin are first-line for VRE. Crucially, daptomycin is inactivated by pulmonary surfactant, rendering it useless for pneumonia.
High‑Yield Points - ⚡ Biggest Takeaways
- Enterococcus faecalis and faecium are key species, often found as normal gut flora.
- They are catalase-negative, PYR-positive, and uniquely grow in 6.5% NaCl.
- A leading cause of nosocomial infections, including UTIs, bacteremia, and endocarditis.
- Known for significant intrinsic and acquired antibiotic resistance, especially Vancomycin-Resistant Enterococci (VRE).
- VRE resistance mechanism involves changing cell wall precursors from D-Ala-D-Ala to D-Ala-D-Lac.
- Treat VRE with Linezolid or Daptomycin.
Unlock the full lesson and continue reading
Signup to continue reading this lesson and unlimited access questions, flashcards, AI notes, and more